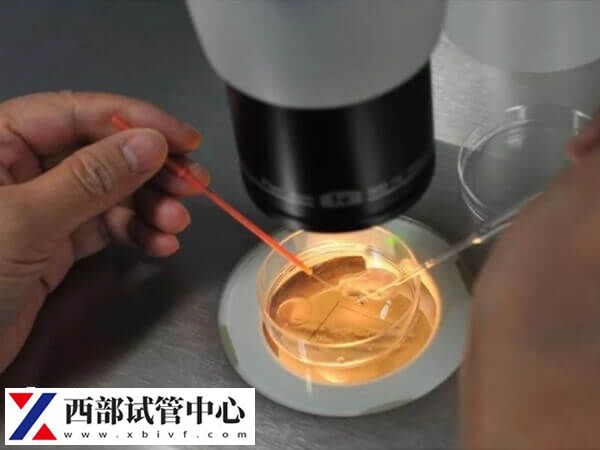
试管移植后48小时如何提高成功率(图2) 试管移植又称体外受精-胚胎移植

试管移植后48小时内是胚胎着床的关键时期,一般建议患者保持适当的休息,但避免长时间保持同一姿势,有利于全身血液循环。其次保持健康营养的饮食,多吃易消化的食物,如蔬菜沙拉、瘦肉或豆制品等,以及心情愉悦,这样能够有效帮助胚胎顺利着床,从而提高着床率。

黄金48小时对试管移植成功率的影响
试管移植是现代医学技术的一项重要成果,但是成功率并不十分稳定。为了让试管移植更加成功,黄金48小时可以说是至关重要的时间段。这时就能够观察到受精卵是否正常发育,进而筛选出最优质的胚胎进行置入
因此在这段时间内采取合理措施能够最大化地提高试管移植的成功率。此外,要注意的是,胚胎刚刚移植到子宫内还是不稳定的,为了帮助胚胎顺利着床,准妈妈们需要使用大量的黄体酮药物来保胎。要严格遵医嘱用药,不可以随意增减药量。
如何利用黄金48小时最大化成功率
试管移植又称体外受精-胚胎移植,是指将女性卵巢中采集到的卵子和男性睾丸中取出的精子在实验室内进行体外受精,然后将受精卵培养成胚胎,再将其植入母体子宫内发育。一般做试管如何利用黄金48小时最大化成功率,可参考下列内容:
1、进行胚胎质量鉴定
在黄金48小时内,医生可以通过显微镜对受精卵进行观察和评估质量。通常情况下,胚胎发育到4细胞或8细胞阶段时,医生会选择最优质的一个或两个受精卵进行移植。因此如果想要提高试管移植的成功率,在这个时间段内需要尽可能地筛选出最优质的受精卵。
2、保持身体放松和舒适
在黄金48小时内,未孕妇女需要保持身体放松和舒适。这样有助于促进血液循环、提高代谢水平,并缓解压力。同时避免过度劳累、睡眠不足等不良习惯也是非常重要的。
3、注意饮食和营养摄入
在IVF-ET周期中,特别是在黄金48小时内,营养摄入对于实现试管移植成功至关重要。花费更多的时间来准备健康且均衡的膳食,保证摄入足够的蛋白质、碳水化合物和脂肪,并且多吃一些富含维生素和矿物质的食品,对于提高试管移植成功率有很大帮助。





